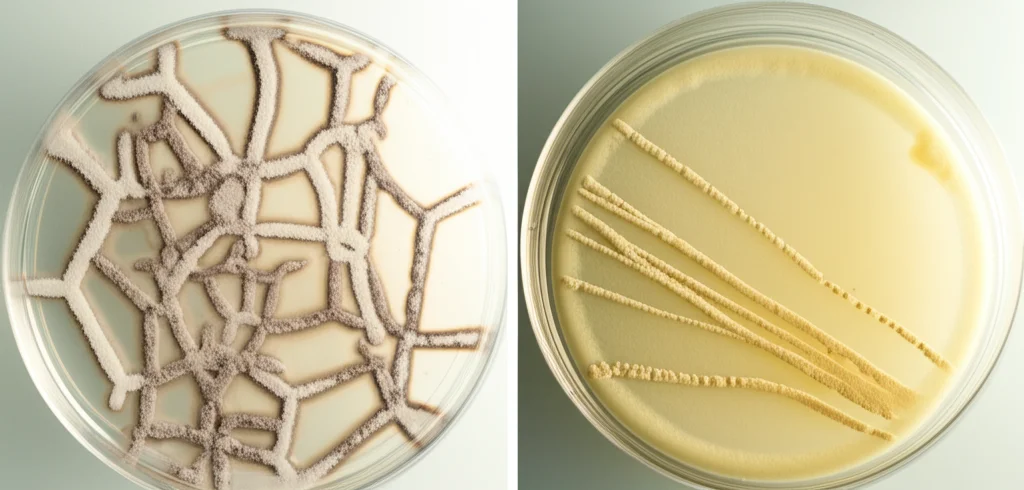
Confronto tra colonie fungine di Rhizopus microsporus su piastre di Petri: una cresciuta normalmente (senza zinco) e una con crescita stentata (con zinco, che riduce 6mA), macro lens, 60mm, illuminazione dall'alto, dettagli morfologici delle ife evidenti, sfondo neutro da laboratorio.

Il Segreto nel DNA di un Fungo Primitivo: La Metilazione Simmetrica dell’Adenina è Vita!
Ciao a tutti, appassionati di scienza e curiosi del mondo microscopico! Oggi voglio portarvi con me in un viaggio affascinante nel cuore del DNA di un organismo davvero particolare, un fungo che appartiene a un lignaggio antichissimo: Rhizopus microsporus. Preparatevi, perché quello che abbiamo scoperto potrebbe riscrivere alcune pagine dell’epigenetica!
Un Intruso Familiare nel DNA Eucariotico
Avete presente la metilazione del DNA? È uno di quei meccanismi “epigenetici” – modifiche chimiche che non alterano la sequenza del DNA ma ne influenzano l’attività, come degli interruttori per i geni. Negli eucarioti come noi, la star indiscussa è la 5-metilcitosina (5mC). Ma da qualche tempo, abbiamo iniziato a trovare anche un’altra modifica, la N6-metiladenina (6mA), tipica più che altro dei batteri. Trovarla negli eucarioti è stata una sorpresa, un po’ come trovare un pinguino nel deserto!
Questa scoperta ha aperto un vaso di Pandora nell’epigenetica. E proprio qui entra in gioco il nostro fungo, Rhizopus microsporus. Non è un fungo qualsiasi: fa parte dei cosiddetti “funghi a divergenza precoce” (EDF), un gruppo che si è separato dagli altri funghi molto tempo fa, conservando caratteristiche uniche. Inoltre, questo Rhizopus è noto per causare gravi infezioni (mucormicosi) e per vivere in simbiosi con batteri. Insomma, un soggetto di studio pieno di sorprese.
La Scoperta Shock: 6mA è Essenziale per la Vita!
Studiando l’epigenoma di R. microsporus, ci siamo imbattuti in qualcosa di incredibile. La 6mA non è solo presente, ma è abbondante (circa l’1.4% di tutte le adenine, molto più che nella maggior parte degli altri eucarioti!) e, udite udite, è essenziale per la sopravvivenza del fungo. Abbiamo scoperto che un complesso proteico, chiamato MTA1c (MT-A70 complex), è responsabile dell’aggiunta di questa modifica 6mA in modo simmetrico (cioè su entrambi i filamenti del DNA nel sito specifico). Ebbene, quando abbiamo provato a eliminare questo complesso… il fungo semplicemente non sopravviveva! Un fenotipo letale. Questo ci dice che la 6mA simmetrica non è un optional per Rhizopus, è una necessità vitale. È la prima volta che si dimostra un ruolo così indispensabile per la 6mA in un organismo multicellulare (sì, i funghi filamentosi come Rhizopus sono considerati tali).
Dove si Trova e Cosa Fa Questa 6mA?
Ma dove si concentra questa modifica così importante? Abbiamo mappato la sua distribuzione nell’intero genoma e abbiamo visto che la 6mA predilige le regioni ricche di geni, quelle che chiamiamo “eucromatina aperta”, zone dove il DNA è più accessibile. In particolare, si trova spesso:
- All’interno dei geni (esoni e introni).
- Subito dopo il punto di inizio della trascrizione (TSS), diminuendo verso la fine del gene.
- Associata a geni attivamente trascritti dall’RNA polimerasi II (quella che produce gli mRNA per le proteine).
- Correlata alla presenza di altre “etichette” epigenetiche associate all’attività genica, come H3K4me3 (una modifica degli istoni) e la variante istonica H2A.Z.
Al contrario, la “classica” metilazione 5mC è rara (circa 0.34%) e si trova principalmente nelle regioni ripetitive del genoma e sugli elementi trasponibili (TEs), suggerendo un ruolo nel silenziamento di queste sequenze “mobili”. Sembra proprio che 6mA e 5mC si siano spartite i compiti in Rhizopus!

6mA, Nucleosomi e l’Orchestra dell’Espressione Genica
Una delle scoperte più affascinanti riguarda il legame tra 6mA e l’organizzazione della cromatina, cioè come il DNA si impacchetta attorno alle proteine istoniche formando i nucleosomi. Abbiamo osservato che la 6mA si trova preferenzialmente nelle regioni “linker”, i tratti di DNA tra un nucleosoma e l’altro. E non è un caso! Sembra che la presenza di 6mA in questi linker influenzi il posizionamento dei nucleosomi, specialmente vicino all’inizio dei geni (TSS).
Pensate ai nucleosomi come a dei “posti di blocco” per l’RNA polimerasi. Se sono ben posizionati e lasciano libero il punto di partenza, il gene può essere trascritto più facilmente. Abbiamo notato che i geni con 6mA mostrano un posizionamento dei nucleosomi più preciso e definito (“well-positioned”) rispetto ai geni senza 6mA, dove la situazione è più “confusa” (“fuzzier”). Inoltre, i geni con 6mA tendono ad essere quelli più espressi. L’ipotesi è che la 6mA nei linker aiuti a “fissare” i nucleosomi in posizioni ottimali, favorendo l’accesso della macchina trascrizionale e quindi l’espressione genica.
Abbiamo anche visto che la 6mA è quasi assente nelle regioni di eterocromatina costitutiva, quelle zone del genoma super-compatte e silenziate, marcate da un’altra modifica istonica, H3K9me3. Invece, abbonda nell’eucromatina attiva, insieme a H3K4me3 e H2A.Z. Si delinea quindi un paesaggio epigenetico ben definito: zone silenziate con H3K9me3 e 5mC, e zone attive con 6mA, H3K4me3 e H2A.Z.
Il Complesso MTA1c: Gli Architetti della 6mA Simmetrica
Ma chi sono i responsabili di questa metilazione essenziale? Come accennato, è il complesso MTA1c. Studiando la sua composizione in Rhizopus e confrontandola con altri organismi, abbiamo confermato la presenza delle proteine chiave:
- Due metiltransferasi di tipo MT-A70 (Mta1 e Mta9), dove Mta1 sembra essere il cuore catalitico.
- Una proteina (P1) con un dominio che lega il DNA (Myb-like).
Questo complesso è conservato in altri organismi ricchi di 6mA (alghe verdi, protisti ciliati e altri funghi EDF), ma assente in piante, animali e funghi “superiori” (Ascomiceti e Basidiomiceti), suggerendo un’origine antica e una perdita successiva in altri lignaggi.
Utilizzando tecniche come il lievito a doppio ibrido (Yeast Two-Hybrid), ChIP-seq (per vedere dove si lega P1 nel genoma in vivo) e DAP-seq (per vedere dove si lega P1 al DNA in vitro), abbiamo confermato le interazioni tra le proteine del complesso e abbiamo visto che P1 si lega preferenzialmente proprio alle regioni ricche di 6mA, vicino all’inizio dei geni attivi e nelle regioni linker tra i nucleosomi. Sembra che il complesso riconosca specifiche sequenze (contenenti AAC) e depositi la 6mA in modo simmetrico.

Regolare l’Interruttore: Gli Effetti della Riduzione di 6mA
Poiché non potevamo eliminare completamente il complesso MTA1c senza uccidere il fungo, abbiamo escogitato un sistema per “abbassare il volume” dell’espressione del gene mta1 (la subunità catalitica) usando un promotore regolabile dallo zinco. Aggiungendo zinco al terreno di coltura, potevamo ridurre l’espressione di mta1 e, di conseguenza, i livelli di 6mA nel genoma (fino a circa il 40% in meno).
Cosa succedeva? Esattamente quello che ci aspettavamo, confermando il ruolo cruciale della 6mA:
- Alterazione dell’espressione genica: Molti geni, soprattutto quelli che perdevano la 6mA vicino al loro inizio, venivano significativamente sotto-regolati (espressi di meno). Questo rafforza l’idea che la 6mA sia un segnale di “accensione” per molti geni.
- Cambiamenti nella cromatina: La riduzione di 6mA portava a una diminuzione della modifica “attivante” H3K4me3 nelle regioni che perdevano la metilazione dell’adenina. Inoltre, l’analisi dei nucleosomi mostrava che diventavano meno posizionati, più “fuzzy”, sia nei geni sotto-regolati che in quelli sovra-regolati (questi ultimi probabilmente usano meccanismi compensatori per attivarsi).
- Fenotipo grave: La crescita del fungo era drasticamente ridotta in presenza di zinco (cioè con meno 6mA), confermando l’essenzialità di questa modifica.
La cosa incredibile è che, togliendo lo zinco e ripristinando l’espressione di mta1, i livelli e la distribuzione della 6mA tornavano quasi identici a prima, suggerendo un meccanismo robusto per il mantenimento di questo pattern epigenetico, forse legato alla replicazione del DNA.
Implicazioni: Dall’Evoluzione a Nuovi Antifungini
Questa ricerca ci dice molto sull’evoluzione dell’epigenetica. Sembra che i funghi EDF, come Rhizopus, abbiano mantenuto (o adottato) la 6mA come principale marchio epigenetico attivante, un ruolo che in altri eucarioti è stato forse preso da altre modifiche. La 6mA in Rhizopus non è solo un marcatore, ma un attore fondamentale che regola l’espressione genica influenzando direttamente la struttura della cromatina e interagendo con altre modifiche istoniche.
E c’è un’implicazione pratica molto importante. La mucormicosi causata da Rhizopus è difficile da trattare, anche perché questi funghi sono resistenti a molti antifungini comuni, e i farmaci disponibili spesso mancano di specificità. Poiché la 6mA simmetrica e il complesso MTA1c sono essenziali per Rhizopus ma rari o assenti negli esseri umani, questo complesso diventa un bersaglio ideale per nuovi farmaci antifungini. Inibire MTA1c potrebbe essere un modo efficace e specifico per combattere queste infezioni devastanti.
Insomma, studiando questo fungo “primitivo”, abbiamo scoperto un meccanismo epigenetico fondamentale e inaspettato, aprendo nuove strade sia per la ricerca di base sull’evoluzione e la regolazione genica, sia per lo sviluppo di terapie innovative. Non è affascinante come i segreti più grandi si nascondano a volte negli organismi più inaspettati? Continueremo a scavare!
Fonte: Springer







